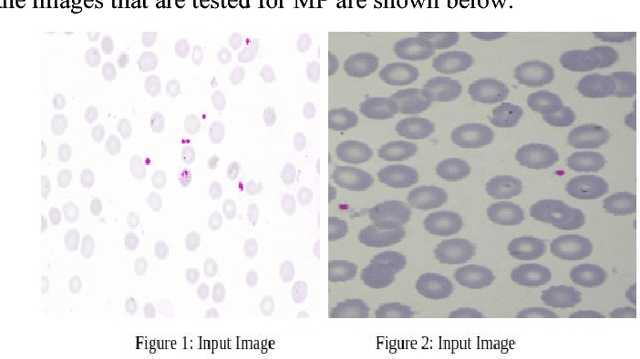
Figure 2 for Malaria Detection Using Image Processing and Machine Learning

Abstract:The increasing number of Health Care facilities in Nepal has also added up the challenges on managing health care waste (HCW). Improper segregation and disposal of HCW leads to the contamination, spreading of infectious diseases and puts a risk of waste handlers. This study benchmarks the state of the art waste classification models: ResNeXt-50, EfficientNet-B0, MobileNetV3-S, YOLOv8-n and YOLOv5-s using Stratified K-fold techniques where we use 5 folds on combined HCW data, and found that the YOLOv5-s achieved higher of 95.06% accuracy but fell short few milliseconds in inference speed with YOLOv8-n model. The EfficientNet-B0 showed promising results of 93.22% accuracy but took the highest inference time. A repetitive ANOVA was performed to see statistical significance and the best performing model (YOLOv5-s) was deployed to the web with mapped bin color using Nepal's HCW management standards for public usage. Further work on the data was suggested along with localized context.
Abstract:With the increasing use of plastic, the challenges associated with managing plastic waste have become more challenging, emphasizing the need of effective solutions for classification and recycling. This study explores the potential of deep learning, focusing on convolutional neural networks (CNNs) and object detection models like YOLO (You Only Look Once), to tackle this issue using the WaDaBa dataset. The study shows that YOLO- 11m achieved highest accuracy (98.03%) and mAP50 (0.990), with YOLO-11n performing similarly but highest mAP50(0.992). Lightweight models like YOLO-10n trained faster but with lower accuracy, whereas MobileNet V2 showed impressive performance (97.12% accuracy) but fell short in object detection. Our study highlights the potential of deep learning models in transforming how we classify plastic waste, with YOLO models proving to be the most effective. By balancing accuracy and computational efficiency, these models can help to create scalable, impactful solutions in waste management and recycling.




Abstract:Interests in digital image processing are growing enormously in recent decades. As a result, different data compression techniques have been proposed which are concerned mostly with the minimization of information used for the representation of images. With the advances of deep neural networks, image compression can be achieved to a higher degree. This paper describes an overview of JPEG Compression, Discrete Fourier Transform (DFT), Convolutional Neural Network (CNN), quality metrics to measure the performance of image compression and discuss the advancement of deep learning for image compression mostly focused on JPEG, and suggests that adaptation of model improve the compression.

Abstract:Malaria is mosquito-borne blood disease caused by parasites of the genus Plasmodium. Conventional diagnostic tool for malaria is the examination of stained blood cell of patient in microscope. The blood to be tested is placed in a slide and is observed under a microscope to count the number of infected RBC. An expert technician is involved in the examination of the slide with intense visual and mental concentration. This is tiresome and time consuming process. In this paper, we construct a new mage processing system for detection and quantification of plasmodium parasites in blood smear slide, later we develop Machine Learning algorithm to learn, detect and determine the types of infected cells according to its features.